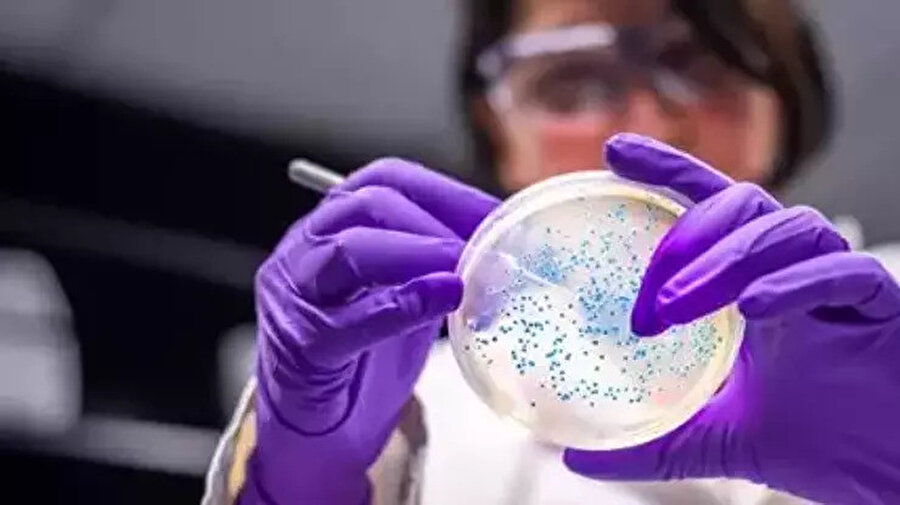

Mutfakta bunları yapıyorsanız dikkat! Uzman isim Salmonella enfeksiyonuna karşı altın kuralları sıraladı

Türkiye genelinde artan gıda zehirlenmesi vakaları, Salmonella kaynaklı enfeksiyon riskini yeniden gündeme taşıdı. Uzmanlar; yetersiz el hijyeni, iyi pişirilmemiş et ve yumurta, güvenilir olmayan sular ile iyi temizlenmeyen sebze-meyvelerin bulaşta etkili olduğuna dikkat çekiyor. Özellikle risk grubundaki bireyler için basit önlemler hayati önem taşıyor.
Türkiye’de son günlerde acil servis başvurularını artıran gıda zehirlenmesi vakaları, Salmonella enfeksiyonu riskine odaklanılmasına neden oldu. Uzman değerlendirmelerine göre, mutfak hijyenindeki ihmaller ve güvenli gıdaya erişimdeki hatalar, enfeksiyonların yayılmasında belirleyici rol oynuyor.
Salmonella nasıl bulaşıyor?
Salmonella bakterisinin başlıca bulaş yolları arasında güvenli olmayan içme suları, yeterince pişirilmemiş tavuk ve kırmızı et, çiğ ya da az pişmiş yumurta ile pastörize edilmemiş süt ürünleri yer alıyor. El yıkama alışkanlıklarının ihmal edilmesi, ortak alanlara temas sonrası gıdaya dokunulması ve kanalizasyon kaynaklı su kirliliği de bulaş riskini artırıyor.
Herkesi etkileyebilir, bazı gruplar daha riskli
Salmonella enfeksiyonu her yaş grubunda görülebilse de yaşlılar, bağışıklığı zayıf bireyler, bebekler ve çocuklar daha ağır seyir riski taşıyor. Bu gruplarda hastaneye yatış gereksinimi ve istenmeyen sonuçlar daha sık görülebiliyor. Belirtiler arasında ateş, karın ağrısı, bulantı, kusma, kramplar ve ishal öne çıkıyor.
Basit önlemlerle risk azaltılabilir
Enfeksiyondan korunmada düzenli ve doğru el yıkama ilk sırada geliyor. Güvenilir su kullanımı, sebze ve meyvelerin bol suyla yıkanması, et ve yumurtanın iyi pişirilmesi, pastörize süt tercih edilmesi önemli adımlar arasında. Ayrıca evcil hayvanların bakım ve temizliğinde hijyene dikkat edilmesi, özellikle sürüngen ve kuşlarla temas sonrası ellerin yıkanması öneriliyor.







